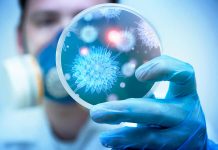
Киевстар выделяет 30 миллионов гривен благотворительной помощи на борьбу с COVID-19 в Украине

Київстар покращує якість 4G у Харкові й області
До Дня міста – 23 серпня – Київстар включив додатко56 базових станцій, що покращить якість мобільного інтернету 4G у самому місті та...
Харьков в 50-е годы (фото)
В конце 40-х и 50-е годы прошлого века харьковчане создали свой город практически заново, таким, каким во многом мы знаем его и...
В Чугуеве пройдет первый в области Museum holiday – «День Ильи в музее Репина»
Мероприятия пройдут с 09:00 до 17:00 по адресам: ул. Музейная, 8, и ул. Соборная, 2.
«День Ильи в музее...
Что смотрели украинцы в первом полугодии 2020 года: данные “Киевстар ТВ”
Компании Киевстар и 1+1 media информируют о результатах работы платформы "Киевстар ТВ" за первое полугодие 2020 года: увеличение активности на 35%, всплеск...
Организация свадьбы в стиле Рустик: идеи и советы
Рустик-стиль в последнее время становится все более популярным среди свадебных торжеств. Он характеризуется использованием натуральных материалов, простотой и уютом. Если вы хотите...
Специально для украинского рынка KIVI презентовала лимитированную серию телевизоров на квантовых точках в честь...
В 2020 году KIVI выпустила свой миллионный телевизор. К этому событию компания подготовила специально для своих клиентов в Украине лимитированную партию устройств...
Киевстар был признан лучшим работодателем Украины
Киевстар стал лидером в двух номинациях "ТОП-100. Рейтинги крупнейших". Компания заняла первое место как Лучший работодатель, а директор по управлению персоналом и...
В Doctor Online доступны бесплатные онлайн консультации с врачами-кардиологами Национального института сердечно-сосудистой хирургии имени...
Киевстар совместно с мобильным сервисом мониторинга здоровья "Доктор онлайн" начал сотрудничество с Национальным институтом сердечно-сосудистой хирургии имени Н. Н. Амосова.
В галерее «Искусство Слобожанщины» откроется выставка «Волшебная Бельгия»
Живопись, графику и коллажи харьковского художника Сергея Гричанка можно посмотреть с 25 февраля по 13 марта.
Сергей Гричанок экспериментирует...
Киевстар выделяет 30 миллионов гривен благотворительной помощи на борьбу с COVID-19 в Украине
Киевстар совместно с БФ "Твоя опора" закупит аппараты искусственной вентиляции легких и мониторы, отслеживающие состояние тяжелобольных пациентов. Остальная помощь будет направлена на...